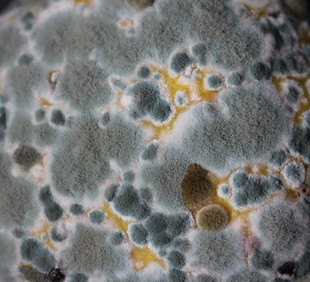

top of page
Our Air Quality Services
At Timeless Home Solutions, we believe fresh, clean air is the foundation of a healthy home. We honor the trust you place in us by caring for the air you and your family breathe every day. Our air quality services help eliminate dust, allergens, mold, and more — giving your family a cleaner, healthier space to call home.
Are You Ready?
Let us serve you with the best care possible. Reach out today to schedule your service. Let’s create a safer, more comfortable space for you and your family.
bottom of page